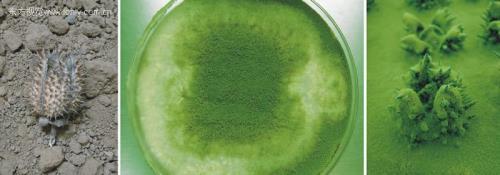

混动汉兰达2022的落地价37.3万元,明细如下。
汉兰达是一款混动车,以汉兰达2022款 双擎 2.5L 四驱尊贵版 7座为例,其官方指导价为329800元,据了解目前淮北市没有什么优惠
如果选择以全款方式来购买的话,商业保险11596元,购置税29186元,上牌费500元,车船使用税750元,交强险950元,最终的落地价是372782元。
汉兰达2022油电混合款落地价
汉兰达2022款双擎2.5L四驱尊贵版7座搭载一套油电混合动力系统,配备2.487LL4发动机和前后永磁同步电动机,发动机最大功率为141kW,峰值扭矩为238牛·米,电动机总扭矩为391牛·米,匹配电子无级变速箱,最高车速为180km/h,工信部综合油耗为5.8L/100km。
再看下配置,汉兰达配备主动刹车/主动安全系统、前/后排头部气囊、主/副驾安全气囊等七项安全性配置。此外,该车还配备了全速域自适应巡航、电动后备厢、后排侧隐私玻璃等十四项舒适便利配置。
价格方面,汉兰达2022款双擎2.5L四驱尊贵版7座的官方指导价为329800元,目前潍坊市没有什么优惠,购置税和车船税等必要花费31296元,再加上商业保险11596元,最终的全款落地价为372692元。